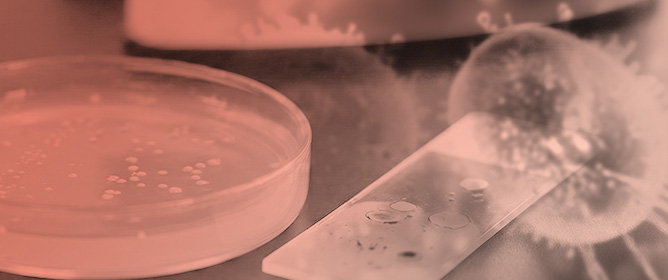
Methenamine as an Alternative Treatment of <em>Neisseria gonorrhoeae</em> Urethritis? An In Vitro and In Vivo Study in <em>Galleria mellonella</em>

Journal Description
Venereology
Venereology
is an international, peer-reviewed, open access journal on venereology research published quarterly online by MDPI.
- Open Access— free for readers, with article processing charges (APC) paid by authors or their institutions.
- Rapid Publication: manuscripts are peer-reviewed and a first decision is provided to authors approximately 22.7 days after submission; acceptance to publication is undertaken in 3.6 days (median values for papers published in this journal in the second half of 2025).
- Recognition of Reviewers: APC discount vouchers, optional signed peer review, and reviewer names published annually in the journal.
Latest Articles
Recent Advances in Human Papillomavirus Prevention in France: Screening, Vaccination, and Lessons from International Experiences
Venereology 2026, 5(2), 12; https://doi.org/10.3390/venereology5020012 - 10 Apr 2026
Abstract
Background/Objectives:Human papillomaviruses (HPVs) are the most common sexually transmitted viruses worldwide and are strongly associated with multiple cancers, including cervical cancer. In France, HPV prevention relies on a combination of organized cervical cancer screening and prophylactic vaccination; however, coverage remains below
[...] Read more.
Background/Objectives:Human papillomaviruses (HPVs) are the most common sexually transmitted viruses worldwide and are strongly associated with multiple cancers, including cervical cancer. In France, HPV prevention relies on a combination of organized cervical cancer screening and prophylactic vaccination; however, coverage remains below international targets. Methods: This narrative review summarizes recent advances in HPV prevention in France, with a focus on screening strategies, including the integration of high-risk HPV testing and vaginal self-sampling, as well as vaccination policies that now include both girls and boys, notably through school-based programs. Results: International comparisons, particularly with Australia and several European countries, are used to highlight successful strategies and transferable lessons that could enhance the effectiveness of French prevention efforts. The review also discusses persistent barriers to uptake, including social, organizational, and cultural factors, and considers opportunities to reduce inequalities in access to prevention. Conclusions: Overall, this work provides a comprehensive overview of the current landscape of HPV prevention in France and situates national efforts within a global public health context, offering insights for policy development and future research directions.
Full article
Open AccessReview
Closing the Gap Between HIV Testing Guidelines and Dermatology: A Narrative Review of Missed Opportunities in Indicator Condition-Guided Testing
by
Maria Gabriella Donà and Alessandra Latini
Venereology 2026, 5(2), 11; https://doi.org/10.3390/venereology5020011 - 1 Apr 2026
Abstract
Background/Objectives: Early diagnosis of HIV remains a key objective of global health strategies; however, nearly half of HIV infections in Europe (47.0%) continue to be diagnosed at a late stage. Individuals with undiagnosed HIV infection frequently present initially to dermatology services with
[...] Read more.
Background/Objectives: Early diagnosis of HIV remains a key objective of global health strategies; however, nearly half of HIV infections in Europe (47.0%) continue to be diagnosed at a late stage. Individuals with undiagnosed HIV infection frequently present initially to dermatology services with inflammatory or pruritic dermatoses. Indicator condition-guided (IC-guided) HIV testing has been reaffirmed by recent guidelines as a central pillar of differentiated testing services, with explicit recommendations to systematically offer testing when defined conditions are present. Methods: This narrative review compares current HIV testing and IC-guided testing recommendations with major dermatology guidelines. Results: This comparison highlights a persistent misalignment. Although certain conditions, such as herpes zoster in younger adults, crusted scabies and selected forms of chronic pruritus, carry clear recommendations to offer HIV testing, most dermatology guidelines for chronic inflammatory dermatoses do not include HIV testing as part of routine assessment. Observational data and implementation studies indicate that integrating IC-guided testing into dermatology pathways can identify previously undiagnosed HIV infections, often in patients without recognised risk factors. Conclusions: Our observations highlight the need to integrate HIV testing recommendations into dermatology clinical guidelines. Aligning these guidelines with IC-guided testing strategies is not only feasible but can also reduce late HIV diagnoses arising from dermatology services.
Full article
(This article belongs to the Special Issue Decoding the Skin: HIV, STIs, and the Venereologist Perspective)
Open AccessFeature PaperArticle
The Aetiology and Treatment Outcomes of Epididymo-Orchitis: A 2025 Clinic-Based Review
by
Jim Abi Frem, Peter Soliman, Colin Fitzpatrick, Deborah Williams and Daniel Richardson
Venereology 2026, 5(1), 10; https://doi.org/10.3390/venereology5010010 - 17 Mar 2026
Abstract
Background: Epididymo-orchitis can be caused by sexually transmitted pathogens, including Neisseria gonorrhoeae, Chlamydia trachomatis, and Mycoplasma genitalium, or entero-bacteria. The aim of this study was to explore the demographics, microbiological findings, and treatment outcomes of patients presenting to a tertiary
[...] Read more.
Background: Epididymo-orchitis can be caused by sexually transmitted pathogens, including Neisseria gonorrhoeae, Chlamydia trachomatis, and Mycoplasma genitalium, or entero-bacteria. The aim of this study was to explore the demographics, microbiological findings, and treatment outcomes of patients presenting to a tertiary sexual health clinic with epididymo-orchitis. Methods: We reviewed the clinical notes of 200 randomly selected patients seen in the clinic with a diagnosis of epididymo-orchitis between 2021 and 2025. We extracted data on demographics, microbiological findings, follow-up, and clinical response rate to treatment. Results: The median age was 33 years (Interquartile range (IQR) = 24–44), 97 (49%) identified as MSM, 11 (6%) were living with HIV (all MSM), and 55 out of the 86 HIV-negative MSM (64%) were using HIV pre-exposure prophylaxis. In total, 35 (18%, 95% confidence intervals = 12.5–23.5%) people were diagnosed with a causative organism: 17 (9%) C. trachomatis, 10 (5%) N. gonorrhoeae, 7 (4%) M. genitalium, 3 (2%) Escherichia coli. Overall, 91 out of 200 (46%) had a documented partner notification plan. Conclusions: A minority of men attending our sexually transmitted infection clinic with clinical epididymo-orchitis have positive microbiology, including M. genitalium. More work is needed to understand the clinical pathophysiology of epididymo-orchitis to streamline treatment algorithms.
Full article
(This article belongs to the Special Issue Global Issues in STIs: Epidemiology, Screening and Treatment—Feature Issue of the Journal Venereology)
Open AccessSystematic Review
Healthcare Professionals’ Beliefs and Concerns About the Use of Doxycycline Post-Exposure Prophylaxis (doxyPEP): A Systematic Review
by
Molly Spence, Clare Fowler, Saxon Absalom, Tom Roper, Deborah Williams and Daniel Richardson
Venereology 2026, 5(1), 9; https://doi.org/10.3390/venereology5010009 - 12 Mar 2026
Abstract
►▼
Show Figures
Objective: To explore healthcare professionals’ beliefs and concerns about doxyPEP by systematically reviewing the literature. Method: A systematic review of three bibliographical databases (CINAHL, EMBASE and MEDLINE) and MedRxiv in August 2024, updated in February 2026 explored healthcare professionals’ beliefs and concerns about
[...] Read more.
Objective: To explore healthcare professionals’ beliefs and concerns about doxyPEP by systematically reviewing the literature. Method: A systematic review of three bibliographical databases (CINAHL, EMBASE and MEDLINE) and MedRxiv in August 2024, updated in February 2026 explored healthcare professionals’ beliefs and concerns about doxyPEP. Three researchers independently reviewed full-text manuscripts for eligibility and narratively synthesized data. We used the Joanna Briggs Institute toolkit to assess risk of bias. This review was registered on PROSPERO (ID:CRD42024570646). Results: Eight manuscripts were included in the final review: five cross-sectional studies, two qualitative studies, and one mixed method study from the USA (n = 5), Australia (n = 1), Kenya (n = 1), and the UK (n = 1) published between 2020–2025 and including 1840 healthcare professionals. Healthcare professionals recognised the high burden of bacterial STIs and believed that doxyPEP should be made available to MSM. There was a strong willingness to provide doxyPEP to MSM with the support of national guidelines. Healthcare professionals suggest that implementing doxyPEP would be feasible with educational support, but were concerned about antimicrobial resistance, drug–drug interactions, pill burden, cost, implementation logistics and the effect on clinical service demands. They acknowledged the lack of research and access to doxyPEP for other groups, specifically trans people and cis-gendered women. They also highlighted the need for community involvement in the implementation of doxyPEP. Conclusions: This review highlights that healthcare professionals were willing and ready to provide doxyPEP; however, they have concerns including antimicrobial resistance, the effect on service capacity, and the lack of research on cis-gendered women and trans people. Patients and health professionals need to be involved in the implementation of doxyPEP.
Full article

Figure 1
Open AccessArticle
UNAIDS 95-95-95 Targets: Progress in HIV Testing (The First 95) as an HIV Prevention Approach Among Orphaned and Vulnerable Children (OVC) in Namibia
by
Enos Moyo, Hadrian Mangwana, Endalkachew Melese, Simon Takawira, Bernadette Harases, Rosalia Indongo, Perseverance Moyo, Ntombizodwa Makurira Nyoni, Pricilla Mbiri and Tafadzwa Dzinamarira
Venereology 2026, 5(1), 8; https://doi.org/10.3390/venereology5010008 - 24 Feb 2026
Abstract
Background: Since the onset of the HIV epidemic, over 40 million individuals have died from AIDS-related illnesses, leading to nearly 14 million children aged 0–17 losing one or both parents to AIDS by 2022. In 2023, Namibia had 250,000 vulnerable children and 72,000
[...] Read more.
Background: Since the onset of the HIV epidemic, over 40 million individuals have died from AIDS-related illnesses, leading to nearly 14 million children aged 0–17 losing one or both parents to AIDS by 2022. In 2023, Namibia had 250,000 vulnerable children and 72,000 children aged 0–17 orphaned due to HIV and AIDS. Without parental support, orphaned and vulnerable children (OVC) face heightened risks, including neglect, distress, and compromised decision-making. These vulnerabilities can increase their susceptibility to risky behaviors, such as sexual experimentation. This study used data from the Project HOPE Namibia (PHN) OVC program to assess HIV testing rates and associated factors among OVC. Methods: This retrospective cross-sectional secondary analysis study used data from PHN’s OVC program implemented from 1 August 2023 to 30 November 2024. Data were analyzed using Chi-square tests and binomial and multinomial logistic regression. Results: Among the 16,995 participants included in this analysis, 15,014 (88.3%) participants had ever been tested for HIV (95% confidence interval (CI): 87.8–88.8%). Participants with an increased likelihood of having ever tested for HIV included those who had been in the program for 0–6 months (adjusted odds ratio (AOR) = 1.31, 95% CI (1.17–1.47)), and those from households experiencing little or moderate hunger (AOR = 1.29, 95% CI (1.12–1.50), AOR = 1.51, 95% CI (1.33–1.72), respectively. Conclusions: A multi-pronged approach involving all stakeholders is required to increase HIV testing among OVC. Such an approach should include community-based HIV testing, providing male-friendly healthcare services, and reducing household hunger through economically empowering vulnerable households.
Full article
Open AccessArticle
Cost-Effectiveness of the Surveillance Strategy for Antimicrobial-Resistant Gonorrhea in the United States: A Modelling Study
by
Sofya Prakhova
Venereology 2026, 5(1), 7; https://doi.org/10.3390/venereology5010007 - 24 Feb 2026
Abstract
Background: The surveillance of antimicrobial-resistant (AMR) gonorrhea in the United States is conducted under the Gonococcal Isolate Surveillance Project (GISP). Its protocol involves the collection of urethral isolates from the symptomatic men diagnosed with urethral gonorrhea at designated surveillance sites and the estimation
[...] Read more.
Background: The surveillance of antimicrobial-resistant (AMR) gonorrhea in the United States is conducted under the Gonococcal Isolate Surveillance Project (GISP). Its protocol involves the collection of urethral isolates from the symptomatic men diagnosed with urethral gonorrhea at designated surveillance sites and the estimation of the percentage of cases resistant to current and former gonorrhea antibiotics. A switch to a new antibiotic is typically made when this percentage for a current first-line drug reaches 5%. However, the cost-effectiveness of this surveillance strategy has never been assessed. Methods: We utilized our previously developed agent-based model of gonorrhea transmission among the US men who have sex with men (MSM) population and estimated the total number of gonorrhea cases, total number of discounted quality-adjusted life years (QALYs) and total discounted costs over 25 years under the current surveillance strategy and under a scenario with no surveillance. Results: The maintenance of the current surveillance strategy is projected to avert 104,108 (95% uncertainty interval: 9163, 213,238) gonorrhea cases, gain 192.9 (95% uncertainty interval: 6, 458.3) QALYs and save $38.6 million (95% uncertainty interval: $1 million, $68.2 million) in the simulated cohort of 10,000 US MSM over a 25-year period (2023–2048) when compared to a scenario with no surveillance. Conclusions: The current US surveillance strategy for AMR gonorrhea is cost-saving. However, the low-bound estimate indicates limited savings of $1 million, which is relatively modest at a national scale.
Full article
(This article belongs to the Special Issue Toward Eliminating Sexually Transmitted Infections: Monitoring, Evaluating Global Progress, Equity and Sustainability)
►▼
Show Figures

Figure 1
Open AccessReview
Chemsex: Venereological Consequences, Psychiatric and Somatic Complications, and Potential Intervention Strategies
by
Hasan Selcuk Ozkan, Stefania-Cristina Rogoveanu and Damla Isman-Haznedaroglu
Venereology 2026, 5(1), 6; https://doi.org/10.3390/venereology5010006 - 2 Feb 2026
Abstract
►▼
Show Figures
Background/Objectives: Chemsex is defined as the intentional use of psychoactive substances to enhance or prolong sexual activity, predominantly observed among men who have sex with men. It has emerged as a notable behavioral and public health concern due to its association with high-risk
[...] Read more.
Background/Objectives: Chemsex is defined as the intentional use of psychoactive substances to enhance or prolong sexual activity, predominantly observed among men who have sex with men. It has emerged as a notable behavioral and public health concern due to its association with high-risk sexual practices, psychiatric morbidity, and somatic complications. Despite increasing recognition, global prevalence estimates vary widely (3–52.5%) due to differences in study populations and methodology. Commonly used substances include synthetic cathinones, amphetamines/methamphetamines, MDMA, GHB/GBL, ketamine, alkyl nitrites, and PDE-5 inhibitors. Methods: A narrative review was conducted using PubMed through 11 December 2025. Search terms combined chemsex-related terminology, substance names, and health outcomes. Recent English-language publications (2020–2025) were prioritized. Evidence was synthesized thematically across epidemiology, health complications, motivations, and interventions. Results: Chemsex is strongly associated with unprotected sex, multipartner encounters, and prolonged intercourse, leading to significantly increased rates of HIV, syphilis, gonorrhoea, and chlamydia. Psychiatric complications include depression, anxiety, compulsive sexual behavior, and psychosis, with higher risks in individuals engaging in slamming or polysubstance use. Somatic complications vary by substance and include cardiovascular disease, hyponatremia, rhabdomyolysis, ulcerative cystitis, methemoglobinemia, and overdose. Motivational factors extend beyond sexual enhancement and include minority stress, internalized and externalized stigma, and maladaptive coping mechanisms. Integrated interventions combining harm reduction, cognitive–behavioral therapy, peer-led services, and pharmacotherapy, alongside digital health tools to support PrEP adherence and risk reduction, show promise in mitigating these harms. Conclusions: Chemsex represents a complex interplay of biological, psychological, and sociocultural factors that contribute to elevated STI risk and psychiatric and somatic morbidity. Addressing chemsex requires destigmatized, multidisciplinary approaches that integrate behavioral, pharmacological, and community-based interventions. Digital health innovations can further enhance engagement, risk reduction, and access to timely care.
Full article

Figure 1
Open AccessArticle
Digital Dating and the Syphilis Surge in Japan: Unraveling the Link Between Technology and STI Trends
by
Yanru Jiang and Yiu-Wing Kam
Venereology 2026, 5(1), 5; https://doi.org/10.3390/venereology5010005 - 20 Jan 2026
Abstract
►▼
Show Figures
Background/Objectives: This study investigates the potential association between the sharp increase in syphilis cases in Japan and the growing popularity of dating apps, with a specific focus on the dynamics during the COVID-19 pandemic. Syphilis, a sexually transmitted infection (STIs) caused by
[...] Read more.
Background/Objectives: This study investigates the potential association between the sharp increase in syphilis cases in Japan and the growing popularity of dating apps, with a specific focus on the dynamics during the COVID-19 pandemic. Syphilis, a sexually transmitted infection (STIs) caused by Treponema pallidum, presents a significant global public health challenge despite being curable with antibiotics. In Japan, the incidence of syphilis has risen dramatically since 2013, surpassing 10,000 reported cases annually by 2022. Methods: To examine this trend, we analyzed the quarterly reported syphilis cases alongside active user data from three major dating apps (App1, App2, and App3) and conducted a stratified linear correlation analysis by gender and age group. Results: The results reveal that syphilis cases showed accelerated growth starting in the first quarter of 2021, and App 3 demonstrated the strongest positive correlation with new syphilis cases. The association was particularly significant among males aged 20–29 (R2 = 0.70, p = 0.0007) and 30–39 (R2 = 0.82, p < 0.0001). Conclusions: These findings suggest that the widespread use of dating apps may contribute to the rise in sexually transmitted infections, including syphilis, by facilitating extensive new sexual contacts. Notably, this trend became increasingly evident during the COVID-19 pandemic. Future STI prevention strategies should consider integrating dating apps as a potential medium for public health interventions. Additionally, strengthening sexual health services is essential to ensure that responses to global crises do not inadvertently undermine STI prevention and control efforts.
Full article

Figure 1
Open AccessArticle
Age-Specific Distribution and Factors Associated with High-Risk HPV Infection and Cervical Lesions Among HIV-Positive and -Negative Women in Maputo, Mozambique: Findings from the HPV-ISI Study
by
Alberto Sineque, Célia Nhambe, Júlia Sebastião, Nilza Cossa, Cacilda Massango, Zita Sidumo, Susanna Ceffa, Fausto Cicacci, Jahit Sacarlal and Maria Clara Bicho
Venereology 2026, 5(1), 4; https://doi.org/10.3390/venereology5010004 - 13 Jan 2026
Abstract
►▼
Show Figures
Background/Objective: High-risk Human papillomavirus (hrHPV) is the leading cause of premalignant lesions and cervical cancer (CC), affecting disproportionally women living with HIV. Mozambique is among the countries with a heavy triple-burden of HIV, hrHPV infections and CC which accounts for more than
[...] Read more.
Background/Objective: High-risk Human papillomavirus (hrHPV) is the leading cause of premalignant lesions and cervical cancer (CC), affecting disproportionally women living with HIV. Mozambique is among the countries with a heavy triple-burden of HIV, hrHPV infections and CC which accounts for more than 5300 new cases and 3800 deaths each year. In this study, we assessed the age-specific distribution and factors associated with hrHPV and cervical lesions among HIV-positive and -negative women from HPV-ISI (HPV Innovative Screening Initiative) study in Maputo, Mozambique. Methods: This cross-sectional study included 1248 non-pregnant women aged ≥18 years who attended CC screening at the DREAM Sant’Egídio Health Centre between July 2021 and April 2022. Screening involved visual inspection with acetic acid (VIA) and high-risk HPV DNA testing. Sociodemographic, lifestyle, and reproductive data were collected through a routine questionnaire. Logistic regression assessed associations between risk factors and hrHPV infection or cervical lesions. Age-specific hrHPV prevalence, partial HPV16/18 genotyping, and abnormal cytology rates were further analyzed by HIV status. Results: The mean age of participants was 43.0 ± 8.6 years. Overall hrHPV prevalence was 28.0%, being higher among HIV-positive women (46.8%) than HIV-negative women (23.8%). Non-16/18 hrHPV genotypes predominated across all age groups. VIA positivity was 11.1%, most frequently involving less than 75% of the cervical area and was more common among younger women (30–45 years) and those living with HIV. Increasing age was associated with lower odds of hrHPV infection (OR = 0.98, 95% CI: 0.97–1.00; p = 0.017), as was higher parity (≥3 deliveries vs. nulliparity: OR = 0.58, 95% CI: 0.36–0.94; p = 0.029). Contraceptive use (OR = 1.65, 95% CI: 1.15–2.38; p = 0.007) and a partially or non-visible squamocolumnar junction (SCJ) (OR = 2.88, 95% CI: 1.74–4.79; p < 0.001) were associated with higher odds of VIA positivity. Conclusions: hrHPV infection and cervical lesions were more frequent in younger and HIV-positive women, highlighting the need for strengthened targeted screening within HIV care services in Mozambique.
Full article

Figure 1
Open AccessArticle
Demographics and Prevalence of HBV, HCV, and Syphilis Among the Female Sex Workers of Daulatdia, Bangladesh: A Cross-Sectional Study
by
Md. Ahsanul Haque, Rahima Begum, Md. Zulfekar Ali, Dewan Zubaer Islam, Ashikur Rahman, Ismail Khalil and Shahad Saif Khandker
Venereology 2026, 5(1), 3; https://doi.org/10.3390/venereology5010003 - 7 Jan 2026
Cited by 1
Abstract
Background: In Bangladesh, a number of sex workers are involved in commercial sex work in different brothels in both legal and illegal settlements due to reasons such as lack of social support, depression, forced sex, abuse, violence, polyamory, being kidnapped, and unemployment.
[...] Read more.
Background: In Bangladesh, a number of sex workers are involved in commercial sex work in different brothels in both legal and illegal settlements due to reasons such as lack of social support, depression, forced sex, abuse, violence, polyamory, being kidnapped, and unemployment. In this study, we tried to evaluate the demographic characteristics and prevalence of viral and sexually transmitted diseases (STDs) among the study population. Methods: A total of 250 female sex workers were interviewed and tested from the Daulatdia brothel of Rajbari district, Bangladesh, who had been working there for at least 1 month. Through questionnaires, demographic data were collected. Primarily, lateral flow immunoassay (LFIA) tests were used to investigate HCV (Hepatitis C Virus), HBV (Hepatitis B Virus), and Syphilis, which were reconfirmed using enzyme-linked immunosorbent assay (ELISA) in cases of positive results. Results: The mean age was 27.51 ± 6.69 years with a range of 18–50 years. Most of them (n = 243, 97.98%) had elementary knowledge of STDs. We determined that overall, 96 (38.40%) were positive for either of these diseases. Individually, 10 (4.00%), 18 (7.20%), and 68 (27.20%) were positive for HCV, HBV, and syphilis, respectively. Conclusions: Our observation indicates that females of all ages should be strictly protected from forced sex work. Current sex workers should be educated regarding the dangers and protective mechanisms of STDs. In addition, as a public health concern, regular clinical check-ups and STD associated diagnoses are necessary to ensure the safety of FSW from these highly infectious and concerning diseases. Due to their socio-economic condition, proper treatment and rehabilitation are highly recommended.
Full article
(This article belongs to the Special Issue Toward Eliminating Sexually Transmitted Infections: Monitoring, Evaluating Global Progress, Equity and Sustainability)
►▼
Show Figures

Figure 1
Open AccessArticle
Determinants of HIV/AIDS Knowledge, Attitudes, and Practices Among High School Students in Burayu Town, Ethiopia
by
Alemayehu Godana Birhanu, Yalemsew Tefera and Fitsum Tigu
Venereology 2026, 5(1), 2; https://doi.org/10.3390/venereology5010002 - 5 Jan 2026
Abstract
►▼
Show Figures
Background: HIV is one of the deadliest viruses in the world and the leading cause of mortality and morbidity in the Sub-Saharan African countries, including Ethiopia. Millions of new HIV infections are reported every year among the population in the 15–24 age group.
[...] Read more.
Background: HIV is one of the deadliest viruses in the world and the leading cause of mortality and morbidity in the Sub-Saharan African countries, including Ethiopia. Millions of new HIV infections are reported every year among the population in the 15–24 age group. Particularly, adolescents are vulnerable to HIV infection due to a lack of adequate information and engagement in risky sexual practices. Thus, the assessment of knowledge, attitudes, and practices (KAPs) is one of the cornerstones in the fight against HIV/AIDS for designing appropriate prevention strategies. This study aimed to assess the KAPs regarding HIV/AIDS among high school students in Burayu town, Ethiopia. Methods: A cross-sectional study design was conducted on students from three higher secondary schools in Burayu town from February to June 2022. A total of 394 students were selected using a stratified proportional sampling technique. Data were collected using pre-tested and self-administered questionnaires and analyzed by SPSS version 26. Descriptive statistics were conducted, and logistic regression was used to determine the associations between variables. A p-value ≤ 0.05 was considered significant in all cases. Results: Out of the 394 students, the majority of respondents (70%) had sufficient knowledge about HIV/AIDS transmission and prevention, while only 61% demonstrated a positive attitude towards people living with HIV/AIDS (PLWHA). In bivariate analysis, a higher level of knowledge was significantly associated with a positive attitude towards PLWHA at OR 23.4, 95% CI, 2.9–185.5, p = 0.003, and not having had sexual practice at OR 4.1, 95% CI, 1.2–13.9, p = 0.025. In multivariate analysis, sexual practice was significantly (p ≤ 0.05) associated with the level of knowledge, age, gender, and places of residence at AORs values of 5.5, 9.7, 3.4, and 5.5, respectively. Conclusions: This study suggests that students with high levels of knowledge had a positive attitude towards PLWHA and less sexual practice compared to students with low levels of knowledge. Furthermore, students’ sexual practice was significantly associated with knowledge level, age, gender, and place of residence. This underscores the urgent need for targeted education to empower vulnerable groups, foster positive attitudes and practive, and curb HIV/AIDS transmission for improved health outcomes.
Full article

Figure 1
Open AccessArticle
Oral Manifestations Among People Living with HIV in Eastern Saudi Arabia: A Cross-Sectional Cohort Study
by
Ali Alsaeed, Reda Kazem Aleid, Mohammed Hashem Abo Alraahi, Arafa Ali Almahroos and Bader Kazem AlEid
Venereology 2026, 5(1), 1; https://doi.org/10.3390/venereology5010001 - 25 Dec 2025
Abstract
Background: Oral manifestations are common among people living with HIV (PLWH) and serve as important clinical indicators of immune status and disease progression. Despite extensive global research, data from the Gulf Cooperation Council region, particularly Saudi Arabia, remain limited. Aims: In this study,
[...] Read more.
Background: Oral manifestations are common among people living with HIV (PLWH) and serve as important clinical indicators of immune status and disease progression. Despite extensive global research, data from the Gulf Cooperation Council region, particularly Saudi Arabia, remain limited. Aims: In this study, we aimed to determine the prevalence of oral manifestations, and their associations with immunological parameters, in a large cohort of PLWH in the Eastern Province of Saudi Arabia. Methods: In this cross-sectional study, we enrolled 1500 adult PLWH who attended the Dammam Medical Complex HIV Clinic between January and December 2023. Demographic, clinical, and laboratory data were collected through medical record review. Standardized oral examinations were performed once per participant by two calibrated dentists using World Health Organization criteria. Statistical analyses included descriptive statistics, chi-square tests, and independent t-tests, with significance set at p < 0.05. Results: The cohort had a mean age of 38.3 ± 11.5 years and was predominantly male (78.3%). Most patients (89.6%) were receiving antiretroviral therapy (ART), with 75.7% achieving viral suppression. The mean CD4 count was 527 ± 221 cells/μL. Common co-infections included hepatitis C virus (11.7%), tuberculosis (17.2%), and hepatitis B virus (4.3%). The prevalence of any HIV-related oral manifestation was 72.9% (n = 1093); the most common findings were xerostomia (subjective dry mouth sensation, 48.1%), oral candidiasis (21.6%), and periodontitis (42.7%). Among severely immunosuppressed patients (CD4 < 200 cells/μL, n = 114), 89.5% had oral manifestations, with oral candidiasis affecting 66.7%. Severe immunosuppression was strongly associated with ART-naive status (92.0% vs. 8.0%, χ2 = 864.55, p < 0.001). The presence of HIV-related oral manifestations was significantly associated with CD4 count < 200 cells/μL (χ2 = 15.96, p < 0.001). Conclusions: HIV-related oral manifestations remain highly prevalent in our large Saudi cohort, despite high ART coverage, with xerostomia and oral candidiasis as the predominant findings. Severe immunosuppression was strongly associated with both ART-naive status and opportunistic oral infections. The association between oral manifestations and immunosuppression underscores their continued clinical relevance as accessible indicators of disease status. Integration of routine oral health screening into HIV care is essential for comprehensive patient management in the region.
Full article
Open AccessArticle
Syphilis Burden and Aneurysm Correction Outcomes in Brazil (2010–2024): Regional Disparities and Economic Impacts
by
Gabriel Kaleb Martins, Sophia Cyane Souza Carvalho, Maria Eduarda Dantas Reis, Grazielly Ferreira Dias, Gabriela Lopes Jesus, João Victor Lima and Cláudio Firmino Dantas
Venereology 2025, 4(4), 16; https://doi.org/10.3390/venereology4040016 - 10 Dec 2025
Abstract
Background: Syphilis, a major sexually transmitted infection, may contribute to cardiovascular complications, impacting hospital outcomes and costs. This study evaluates the association between syphilis burden and hospitalization outcomes (cost, length of stay, and aneurysm mortality) across Brazilian regions from 2010 to 2024. Methods:
[...] Read more.
Background: Syphilis, a major sexually transmitted infection, may contribute to cardiovascular complications, impacting hospital outcomes and costs. This study evaluates the association between syphilis burden and hospitalization outcomes (cost, length of stay, and aneurysm mortality) across Brazilian regions from 2010 to 2024. Methods: Using Brazil’s national healthcare database (n = 405 state-year observations), we classified states by syphilis burden (high, low, intermediate) based on hospitalization rates. Outcomes included average hospitalization cost (R$), length of stay (days), and aneurysm mortality rate (per 100,000). Descriptive statistics, non-parametric tests, ANCOVA models adjusted for hospital complexity and year, and sensitivity analyses (alternative thresholds, outlier removal) were conducted. Regional trends and economic impacts were assessed. Results: High syphilis burden was associated with shorter hospital stays (β = 2.11, p = 0.0008, Cohen’s d = −0.484, power = 0.937) but not with cost (β = 37.6, p = 0.758) or mortality (β = −0.077, p = 0.951). Syphilis incidence correlated moderately with hospitalizations (r = 0.422) but not with aneurysm mortality (Spearman ρ = −0.065, p = 0.193). Total costs (2010–2024) were R$17.7 M (high burden), R$1.9 M (low), and R$12.0 M (intermediate). Regional analyses revealed significant interactions in Nordeste and Norte for length of stay (p = 0.013–0.033). Sensitivity analyses confirmed robustness (Adjusted R2 = 0.049–0.273). Conclusion: High syphilis burden is linked, ecologically, to reduced hospital stays, potentially reflecting fewer complex cases, with substantial economic costs. Regional disparities highlight the need for targeted STI prevention. These findings inform health policy to mitigate syphilis-related hospital burdens in Brazil.
Full article
(This article belongs to the Special Issue Toward Eliminating Sexually Transmitted Infections: Monitoring, Evaluating Global Progress, Equity and Sustainability)
►▼
Show Figures

Figure 1
Open AccessArticle
Diagnostic Utility of Human Papilloma Virus Testing in Comparison with Pap Cytology and Histopathology in Unvaccinated Women with Cervical High-Grade Dysplasia and Carcinoma in Botswana
by
Patricia Setsile Rantshabeng, Nametso Dire, Andrew Khulekani Ndlovu and Ishmael Kasvosve
Venereology 2025, 4(4), 15; https://doi.org/10.3390/venereology4040015 - 17 Nov 2025
Abstract
Background/Objective: High-risk human papillomavirus (hrHPV) is an established causative agent for the malignant transformation of cervical cells that can be detected using the Papanicolaou (Pap) smear test. A call by the World Health Organization (WHO) for global collective efforts towards eliminating cervical cancer
[...] Read more.
Background/Objective: High-risk human papillomavirus (hrHPV) is an established causative agent for the malignant transformation of cervical cells that can be detected using the Papanicolaou (Pap) smear test. A call by the World Health Organization (WHO) for global collective efforts towards eliminating cervical cancer has endorsed hrHPV DNA testing as an alternative screening test. The objective of this study was to determine the diagnostic utility of hrHPV DNA testing in detecting high-grade cervical intraepithelial lesions (HSILs) in unvaccinated women with abnormal Pap smears and histopathologically confirmed CIN3 and carcinoma. Methods: This study included 111 cervical tissues with a histopathological confirmation of the cervical intraepithelial neoplasia grade (CIN3) and malignancy. Tissues were sectioned, dewaxed, and digested, and DNA was extracted and tested for hrHPV using the Abbott RealTime HR HPV assay. Pap smear results associated with the tissue samples were extracted from corresponding clinical records, and data was analyzed using R-statistical software. Results: Extracted Pap smear records for the 111 cervical tissue samples indicated that 89 (80.2%) had a high-grade intraepithelial lesion (Pap-HSIL), 20 (18%) had squamous cell carcinoma (Pap-SCC), and two (1.8%) had Pap-adenocarcinoma. A total of 68/89 (76.4%) of Pap-HSIL, 15/20 (75%) of Pap-SCC, and ½ (50%) of Pap-adenocarcinoma cases had detectable hrHPV DNA. Conclusions: This study’s findings demonstrate that the Pap smear is still a valuable screening test especially for detecting both hrHPV-dependent and -independent cervical dysplasia in unvaccinated populations. While considerations are made to improve cervical cancer screening, including the introduction of hrHPV DNA testing in national cervical cancer screening programs, there is a need for the careful interpretation of molecular testing results for clinical intervention. This is especially important for hrHPV-independent cervical dysplasia screening, since this can have dire implications for clinically asymptomatic women.
Full article
(This article belongs to the Special Issue Toward Eliminating Sexually Transmitted Infections: Monitoring, Evaluating Global Progress, Equity and Sustainability)
►▼
Show Figures

Figure A1
Open AccessArticle
Integrating Reverse Vaccinology with Immunoinformatics for Rational Vaccine Target Discovery in Mycoplasma genitalium
by
Jyoti Taneja, Ravi Kant and Daman Saluja
Venereology 2025, 4(3), 14; https://doi.org/10.3390/venereology4030014 - 22 Sep 2025
Cited by 1
Abstract
►▼
Show Figures
Background: The increasing prevalence of antibiotic-resistant Mycoplasma genitalium poses a significant challenge to global public health, necessitating the exploration of alternative therapeutic strategies, including vaccine development. Methods: In this study, we employed an immuno-informatics-based reverse vaccinology approach augmented with artificial intelligence-driven
[...] Read more.
Background: The increasing prevalence of antibiotic-resistant Mycoplasma genitalium poses a significant challenge to global public health, necessitating the exploration of alternative therapeutic strategies, including vaccine development. Methods: In this study, we employed an immuno-informatics-based reverse vaccinology approach augmented with artificial intelligence-driven tools, to identify and characterize potential B-cell and T-cell epitopes from the hypothetical proteins (HPs) retrieved from the genome of the MG_G37T strain, a previously uncharacterized yet promising vaccine target. Using multiple softwares, a systematic pipeline was utilized to assess the sub-cellular localization, antigenicity, and allergenicity of the selected proteins. Results: Sub-cellular localization analysis identified the presence of several outer membrane and extracellular proteins in the genome of MG_G37T, indicating their surface association and accessibility to immune surveillance. Antigenicity and allergenicity prediction tools led to the identification of two top-scoring hypothetical proteins (fig|2097.71.peg.1 (UniProt ID: P22747) and fig|2097.70.peg.33 (UniProt ID: Q57081)) that demonstrated strong antigenic potential, non-allergenic properties, and suitability as vaccine candidates. Epitope mapping and structural modeling analyses further validated the immunogenic potential of these epitopes, highlighting their ability to interact with host immune components effectively. Comparative analyses with mouse allelic regions indicated the potential translational relevance of these predicted epitopes for preclinical studies. Conclusions: In particular, this study highlights the potential of these two hypothetical proteins as a promising vaccine candidate and provides a strong reason for experimental validation towards the design and development of effective vaccines to combat M. genitalium infections in the era of antimicrobial resistance.
Full article

Figure 1
Open AccessFeature PaperArticle
Methenamine as an Alternative Treatment of Neisseria gonorrhoeae Urethritis? An In Vitro and In Vivo Study in Galleria mellonella
by
Izumo Kanesaka, Saïd Abdellati, Sheeba Santhini Manoharan-Basil and Chris Kenyon
Venereology 2025, 4(3), 13; https://doi.org/10.3390/venereology4030013 - 1 Aug 2025
Abstract
►▼
Show Figures
Background: There is an urgent need for novel treatment options for Neisseria gonorrhoeae. Methenamine is an interesting urinary antiseptic with a very low propensity to induce antimicrobial resistance. Methods: We assessed the MICs of methenamine-hippurate for 18 N. gonorrhoeae isolates. We then
[...] Read more.
Background: There is an urgent need for novel treatment options for Neisseria gonorrhoeae. Methenamine is an interesting urinary antiseptic with a very low propensity to induce antimicrobial resistance. Methods: We assessed the MICs of methenamine-hippurate for 18 N. gonorrhoeae isolates. We then assessed the in vivo efficacy of methenamine-hippurate against N. gonorrhoeae using the Galleria mellonella infection model. Results: We found that all the gonococcal isolates had a methenamine-hippurate MIC of 300 mg/L. This MIC was not higher in isolates with higher ceftriaxone MICs. No toxicity of methenamine at the doses tested was found, and doses as low as 200 mg/kg were effective in the G. mellonella model. Conclusions: Further studies in mice and humans are required to assess if methenamine-hippurate could be used to treat gonococcal urethritis alone or in combination with other agents such as ceftriaxone.
Full article

Figure 1
Open AccessArticle
Evaluating the Antibiotic Resistance Patterns in Mycoplasma hominis and Ureaplasma spp. Infections in Salvador, Brazil
by
Sofia Lírio Santos Silva, Larissa Vieira do Amaral, Raissa Vieira do Amaral, Maria Isabel Figueiredo Sousa, Mauricio Freitas Batista, Maria Betânia Toralles, Caroline Alves Feitosa, Galileu Barbosa Costa and Viviane Matos Ferreira
Venereology 2025, 4(3), 12; https://doi.org/10.3390/venereology4030012 - 19 Jul 2025
Abstract
►▼
Show Figures
Background/Objectives: Mycoplasma and Ureaplasma species are pathogens commonly associated with urogenital infections in sexually active individuals. Despite their clinical relevance, these organisms are less frequently studied than other sexually transmitted infections (STIs), leading to limited data on their antimicrobial susceptibility and resistance
[...] Read more.
Background/Objectives: Mycoplasma and Ureaplasma species are pathogens commonly associated with urogenital infections in sexually active individuals. Despite their clinical relevance, these organisms are less frequently studied than other sexually transmitted infections (STIs), leading to limited data on their antimicrobial susceptibility and resistance profiles. This study aimed to characterize the antimicrobial susceptibility and resistance patterns of Mycoplasma hominis and Ureaplasma spp. among individuals in Salvador, Bahia, Brazil, and to identify the potential associated risk factors. Methods: We conducted a retrospective descriptive study during 2022–2024 using secondary data obtained from the SMARTLab® diagnostic system. Sociodemographic and epidemiological data, along with results from IST2 and IST3 diagnostic tests, were analyzed. Absolute and relative frequencies were calculated by sex, age group, and antimicrobial susceptibility profile. Results: Our results revealed a predominance of M. hominis and Ureaplasma spp. infection among women (98.5%), and in individuals aged 38 to 47 years. Ureaplasma spp. accounted for the majority of positive cases. High rates of resistance were observed in the IST2 test, with 75.0% of M. hominis and 84.1% of Ureaplasma urealyticum resistant to ciprofloxacin. In the IST3 test, Ureaplasma spp. demonstrated a 7.3% resistance rate to levofloxacin, which increased to 22.2% in cases of co-infection. Conclusions: These findings underscore the growing threat of antimicrobial resistance in Mycoplasma and Ureaplasma species and highlight the need for targeted public health strategies and diagnostic tools to manage infections caused by these organisms, particularly in high-risk populations.
Full article

Figure 1
Open AccessReview
A Scoping Review of How High-Income Country HIV Guidelines Define, Assess, and Address Oral ART Adherence
by
Dominic Chu, Kim Engler, Tibor Schuster, Romain Palich, Joel Ishak and Bertrand Lebouché
Venereology 2025, 4(3), 11; https://doi.org/10.3390/venereology4030011 - 1 Jul 2025
Abstract
►▼
Show Figures
Background/Objectives: An optimal approach to addressing oral antiretroviral therapy (ART) adherence remains unclear in the research literature. This review aimed to identify definitions and thresholds of adherence, proposed methods and frequencies of evaluating adherence levels, barriers to adherence, and interventions to address adherence
[...] Read more.
Background/Objectives: An optimal approach to addressing oral antiretroviral therapy (ART) adherence remains unclear in the research literature. This review aimed to identify definitions and thresholds of adherence, proposed methods and frequencies of evaluating adherence levels, barriers to adherence, and interventions to address adherence problems. Methods: A scoping review of HIV guidelines drew on guidance from the Joanna Briggs Institute. Eligible English and French guidelines and their updates concerned adults with HIV and oral ART from developed countries and international health organizations from 2017 to May 2023. Three databases were systematically searched, along with the gray literature. Then, a targeted search for omitted developed countries was conducted. Document selection and data charting were performed with two reviewers for 20% of records and full texts, followed by an independent review. Inductive–deductive content analysis of extracted data was performed using NVivo 14 software. Results: Twenty-four guidelines were identified from seven countries and two international health organizations. Only two defined ART adherence, and none offered a threshold for adequate adherence. Most guidelines (n = 22/24) reported adherence interventions, 20 guidelines (83%) identified adherence barriers, 20 guidelines (83%) noted variable methods to evaluate adherence, and 17 guidelines (71%) proposed a range of frequencies for assessing adherence. Conclusions: This review underscored a lack of consensus around adherence and its management. Very few guidelines defined adherence, none proposed an optimal threshold, and there was no agreement on how to gauge adherence. These gaps and variability raise questions about how clinicians manage adherence in practice. More systematic and preventative approaches to monitoring adherence may be needed.
Full article

Figure 1
Open AccessCase Report
Piercing Through: Lefamulin Treatment of an Antibiotic-Resistant Mycoplasma Genitalium Urethritis
by
Shukai Yuchi, Noa Slotky, Laurence Moore and Rob Striker
Venereology 2025, 4(3), 10; https://doi.org/10.3390/venereology4030010 - 26 Jun 2025
Cited by 1
Abstract
►▼
Show Figures
Multidrug-resistant (MDR) Mycoplasma genitalium (M. genitalium) presents a significant risk of treatment failure in many sexually transmitted infections (STIs) and can result in persistent and recurrent urethritis or cervicitis. This case report describes a recurrent M. genitalium urethritis resistant to sulfamethoxazole-trimethoprim
[...] Read more.
Multidrug-resistant (MDR) Mycoplasma genitalium (M. genitalium) presents a significant risk of treatment failure in many sexually transmitted infections (STIs) and can result in persistent and recurrent urethritis or cervicitis. This case report describes a recurrent M. genitalium urethritis resistant to sulfamethoxazole-trimethoprim (TMP-SMX), doxycycline, and moxifloxacin. The infection was ultimately cured after both the removal of a nidus of infection and through the use of Lefamulin. Lefamulin is a novel agent approved for use in community-acquired bacterial pneumonia and bacterial skin infections that may be useful in difficult sexually transmitted infections. Background/Objectives: Deciding whether or not to treat M. genitalium can be challenging as it can be a colonizer, or present with a symptomatic pathogen, and even if it is causing symptoms, it can be drug-resistant. Our objective here is to highlight important considerations on whether or not to treat and, if so, what options exist. Conclusions: In a world of increasing drug-resistant STIs, this case highlights the challenges of managing MDR M. genitalium and how foreign bodies can allow reoccurrence. Also highlighted in this case, Lefamulin appears to be a viable alternative line of treatment of MDR M. genitalium that defies other first-line antibiotics.
Full article

Figure 1
Open AccessArticle
Metabolic Syndrome Among People Living with Human Immunodeficiency Virus (HIV) Receiving Antiretroviral Therapy in Mexico
by
Tatiana Ordóñez-Rodríguez, Luis Antonio Leyva-Alejandro, José Manuel Reyes-Ruiz, Gustavo Martínez-Mier, Roberto Carlos Cortes-Balán, Oscar Faibre-Álvarez, Judith Quistián-Galván, Wendy Marilú Ramos-Hernández and Víctor Bernal-Dolores
Venereology 2025, 4(2), 9; https://doi.org/10.3390/venereology4020009 - 14 Jun 2025
Cited by 1
Abstract
Background/Objectives: In Mexico, there is very little data on the prevalence of metabolic syndrome in people living with human immunodeficiency virus (HIV) receiving antiretroviral therapy (ART), so, determining the number of people with this condition will help to establish measures to treat it
[...] Read more.
Background/Objectives: In Mexico, there is very little data on the prevalence of metabolic syndrome in people living with human immunodeficiency virus (HIV) receiving antiretroviral therapy (ART), so, determining the number of people with this condition will help to establish measures to treat it promptly. Methods: A descriptive, observational, prospective, cross-sectional study was conducted in a cohort of people living with HIV who signed the informed consent form and were stratified according to the criteria established by the Adult Treatment Panel III (ATP-III) and the Latin American Diabetes Association (ALAD) for the diagnosis of metabolic syndrome. Results: According to the ATP-III and ALAD criteria, 26.5% and 36.3% of people living with HIV receiving ART were diagnosed with metabolic syndrome, respectively. Metabolic syndrome was more prevalent in men than in women, using both classification criteria (ATP-III: 58 men [67.4%] vs. 28 women [32.6%]; ALAD: 84 men [71.2%] vs. 34 women [28.8%]). The median time since HIV diagnosis of the participants with metabolic syndrome was longer than for the participants without metabolic syndrome, using the ALAD criteria (p = 0.023). The time spent on ART among participants with metabolic syndrome was longer than among those without, using the ATP-III criteria (p = 0.011). The CD4+ T-cell count and HIV-RNA detection showed no significant difference between participants with and without metabolic syndrome (p > 0.05). No statistical significance was found concerning ART and metabolic syndrome; it is noteworthy that for participants with dolutegravir/abacavir/lamivudine (DTG/ABC/3TC), the frequency was similar regardless of the criteria used, and different for those who were taking bictegravir/emtricitabine/tenofovir alafenamide (BIC/FTC/TAF) or were in other schemes (etravirine, darunavir/ritonavir, raltegravir). Conclusions: Our results suggested that 26.5% and 36.3% of the people living with HIV receiving ART included in this study had metabolic syndrome according to ATP-III and ALAD criteria, respectively. These results are consistent with results reported in the Latin American population. Interestingly, both criteria showed a higher frequency of metabolic syndrome in men living with HIV compared to women.
Full article
(This article belongs to the Special Issue New Advances in Management and Treatment of Sexually Transmitted Infections)
Highly Accessed Articles
Latest Books
E-Mail Alert
News
Topics

Special Issues
Special Issue in
Venereology
Toward Eliminating Sexually Transmitted Infections: Monitoring, Evaluating Global Progress, Equity and Sustainability
Guest Editors: Phuong The Nguyen, Stuart GilmourDeadline: 31 August 2026
Special Issue in
Venereology
Decoding the Skin: HIV, STIs, and the Venereologist Perspective
Guest Editor: Alessandra LatiniDeadline: 31 December 2026
Special Issue in
Venereology
Global Issues in STIs: Epidemiology, Screening and Treatment—Feature Issue of the Journal VenereologyGuest Editor: Michael RossDeadline: 30 April 2027